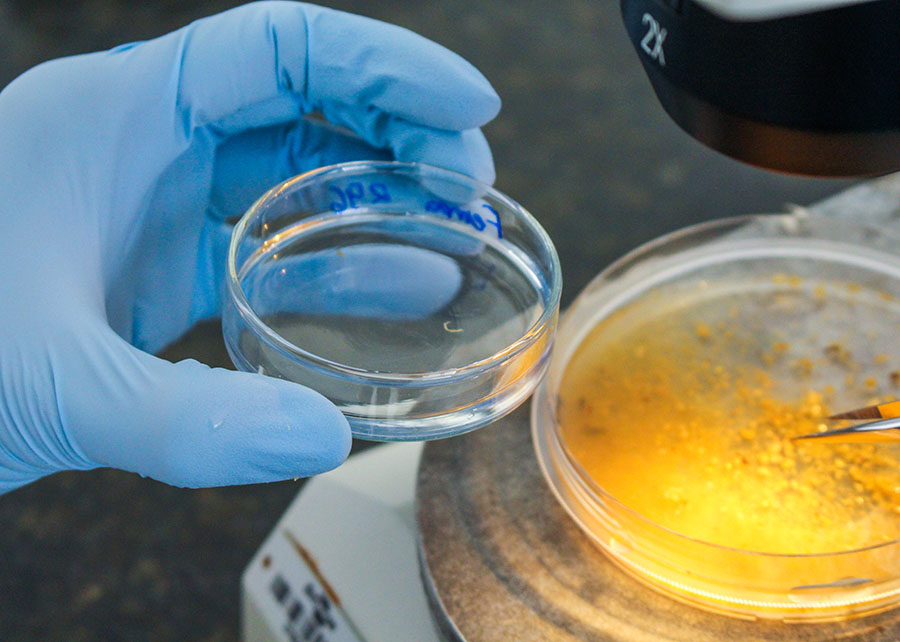

A descoberta favorece a diminuição do uso de anti-helmínticos, medicamentos usados para controlar esses vermes.
Um estudo da Embrapa Pecuária Sudeste (SP) identificou proteínas relacionadas à infecção por vermes em ovinos. Foram analisadas raças suscetíveis (Dorper) e resistentes (Santa Inês) a esses parasitas. A pesquisa, publicada na Revista Internacional Veterinary Parasitology, fornece informações sobre os mecanismos de defesa dos animais com diferentes habilidades para resistir à infecção. A descoberta favorece a diminuição do uso de anti-helmínticos, medicamentos usados para controlar esses vermes.
Os resultados do estudo colaboram para a seleção de animais e raças ovinas mais resistentes. A seleção é uma ferramenta para controle de parasitas de importância veterinária na produção de pequenos ruminantes em áreas tropicais. A caracterização das proteínas do sangue é capaz de revelar biomarcadores dos animais mais doentes, bem como monitorar condições fisiológicas e metabólicas críticas para o bem-estar e a saúde dos ovinos.
Para a identificação e quantificação das proteínas, a pesquisadora Ana Carolina Chagas, que coordenou o trabalho, aplicou a técnica proteômica à produção animal tropical, contando com o apoio de parceiros do Instituto Superior de Agronomia, da Universidade de Lisboa, e da Universidade do Porto. Essa técnica consiste em estudar a distribuição, modificações, interações e funções de uma ou mais proteínas em uma célula ou organismo. A determinação de raças e indivíduos resistentes à verminose é importante para se reduzir o impacto negativo dos parasitas, como o Haemonchus contortus.
Proteínas detectadas
Os cordeiros infectados foram avaliados semanalmente na Embrapa, durante 28 dias. No fim do experimento, houve diferença significativa entre as duas raças em relação às infecções por meio das análises de contagem de ovos por grama de fezes (OPG) dos animais, que mede o grau da infecção, e avaliação do volume globular (VG), que mede o grau de anemia desencadeada pelos vermes.
A maior ou menor quantidade de determinadas proteínas indicou impactos relevantes no organismo do animal para a proteção em relação à infecção ou aos danos causados pelas inflamações. Algumas proteínas foram encontradas nas duas raças, com diferenças quantitativas significativas. Esses resultados demonstram como a infecção pode impactar o desenvolvimento e o ganho de peso dos cordeiros.
Segundo Chagas, foram detectadas proteínas associadas ao sistema imune ao se comparar as raças Santa Inês e Dorper (foto de cordeiro da raça à direita). Outras proteínas foram ligadas à resposta ao estresse do manejo, amostragem e calor, e ao controle ou não da inflamação. “Por exemplo, a enzima enolase fosfopiruvato hidratase, ou ENO3, desempenha um papel relevante no sistema imunológico da Santa Inês, enquanto a Themis parece contribuir na resposta imune da Dorper. Por sua vez, as proteínas de fase aguda detectadas, as APPs, indicam infecções, inflamações e condições de estresse”, explica a pesquisadora. Ela reforça que essas proteínas possuem potencial como biomarcadores para tratamentos seletivos.

Resultados
Animais resistentes aos parasitas gastrintestinais são capazes de desenvolver uma resposta imune mais rápida e robusta, limitando o estabelecimento das larvas, suprimindo o crescimento dos parasitas adultos, diminuindo a fecundidade das fêmeas, ou promovendo a expulsão dos Haemonchus contortus adultos. A pesquisa utilizando a proteômica forneceu informações inéditas e uma compreensão mais abrangente sobre a infecção por essa espécie de parasita. Foi possível realizar a diferenciação entre as duas raças estudadas, e entre animais infectados e não infectados da mesma raça.
O estudo revelou, por exemplo, que as proteínas APPs usuais, como alfa-1-glicoproteína ácida, haptoglobina, proteína amiloide A sérica e ceruloplasmina indicam condições relacionadas à infecção, inflamação e estresse. Outro avanço foi que o trabalho revelou uma rota imunológica diferente da encontrada na raça Santa Inês.
Proteínas relacionadas ao desenvolvimento, crescimento e acúmulo de gordura em cordeiros, como a Aggrecan Core Protein (ACAN), apareceram reduzidas em cordeiros infectados de ambas as raças, sugerindo que essas atividades são prejudicadas pela presença do H. contortus, impactando negativamente a produção.
Já a gasdermina-D (GSDMD), historicamente relacionada à inflamação do trato gastrintestinal humano, e a proteína ligadora de guanilato (GBP) apresentaram-se em abundância nos cordeiros Dorper infectados. Ambas as proteínas aumentadas, com a ACAN reduzida, podem ser biomarcadores de animais infectados.
Portanto, os resultados indicam que as duas raças estudadas têm metabolismo e resposta imunológica distintas frente à infecção. Diferenças quantitativas em proteínas compartilhadas podem contribuir para o desenvolvimento de biomarcadores e auxiliar na determinação do status de infecção de ovelhas, que poderão ser tratadas seletivamente no rebanho. 
“É uma alternativa para reduzir o uso de vermífugos e diminuir os casos de resistência de parasitas. No entanto, o controle da verminose depende de vários fatores, principalmente de ações nas propriedades e conscientização dos produtores de ovinos de evitarem o uso indiscriminado de anti-helmínticos”, ressalta a pesquisadora.
Prejuízos de US$ 100 milhões
Estima-se que, no Brasil, as doenças gastrintestinais levam a perdas de até 27% no ganho de peso de cordeiros criados a pasto, atingindo US$ 94,5 milhões por ano. Já as relacionadas à morte de animais ficam em torno de US$ 13 milhões anuais. O rebanho brasileiro chega a quase 20 milhões de ovinos, número ainda insuficiente para atender à demanda interna.
Os parasitas gastrintestinais são responsáveis por restringir a produção ovina, porque limitam o desempenho animal. O principal verme que ameaça ovinos é da espécie Haemonchus contortus, mais frequente nos pequenos ruminantes em regiões tropicais e subtropicais, causando anemia grave, edema submandibular e morte por hematofagia.
Para tentar controlar o problema, os produtores de ovinos acabam fazendo uso indiscriminado de anti-helmínticos, o que resulta na resistência dos parasitas, diminuindo a eficácia de seu controle. “Ferramentas tecnológicas capazes de identificar os mais parasitados do rebanho são importantes para promover um controle mais preciso, preservando os compostos anti-helmínticos que ainda são eficazes”, explica Chagas. 
Fonte: Embrapa
VEJA TAMBÉM:
- Preços do café oscilam conforme condições climáticas
- Algodão em pluma fecha abaixo dos R$ 4/lb
- Paralisação de trens no Canadá pode afetar agricultura na América do Norte
ℹ️ Conteúdo publicado por Myllena Seifarth sob a supervisão do editor-chefe Thiago Pereira
Quer ficar por dentro do agronegócio brasileiro e receber as principais notícias do setor em primeira mão? Para isso é só entrar em nosso grupo do WhatsApp (clique aqui) ou Telegram (clique aqui). Você também pode assinar nosso feed pelo Google Notícias
Não é permitida a cópia integral do conteúdo acima. A reprodução parcial é autorizada apenas na forma de citação e com link para o conteúdo na íntegra. Plágio é crime de acordo com a Lei 9610/98.